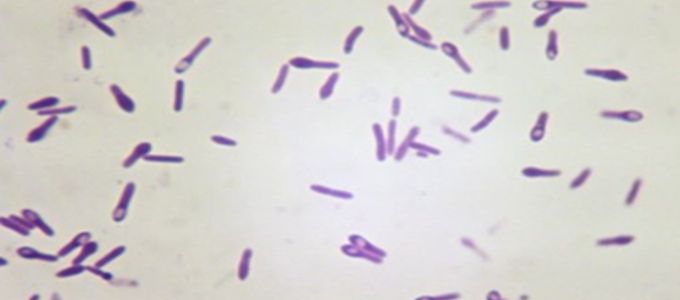
Necrotic Enteritis in Pigs - The Disease

Tilmovet AC is also for the control of swine respiratory disease associated with Mycoplasma hyopneumoniae in the presence of Porcine Reproductive and Respiratory Syndrome Virus (PRRSV) in groups of swine in buildings where a respiratory disease outbreak is diagnosed. Comprised of the active ingredient tilmicosin phosphate, Tilmovet AC is a bio-equivalent product to Pulmotil® AC.
"We are thrilled to continue our commitment to building a broad portfolio for the swine industry with the recent approval of our Tilmovet AC. This addition is complementary to our current product offering, but will also play an important role as we look to future growth of Huvepharma's swine portfolio," says Drew Weir, Director of Huvepharma's Integrator Business Unit.
Tilmovet AC is the first generic aqueous concentrate approved by the FDA that controls swine respiratory disease associated with Mycoplasma hyopneumoniae in the presence of PRRSV in groups of swine in buildings where a respiratory disease outbreak is diagnosed. This approval further demonstrates Huvepharma's commitment to providing producers with quality and effective choices.
Dr. David Nolan, Sr. veterinarian on Huvepharma's swine team, sums up our excitement with these words; "It is with great excitement that the Huvepharma swine team is bringing Tilmovet AC to the US pig industry. This new choice represents Huvepharma's ongoing commitment to bringing solutions to the veterinarians and producers we serve. Our Tilmovet AC product will be a welcome addition to the ongoing battle against swine respiratory disease. When you have choices, you have control!"
Throughout the US, Huvepharma is focused on building partnerships with industry customers by offering high quality products and unparalleled customer service. For more information, please contact your Huvepharma sales representative and/or Huvepharma's Customer Service team at +1-887-994-4883 or visit www.huvepharma.us.
Warning
Exposure to tilmicosin in humans has been associated with chest pain, increased heart rate, dizziness, headache, and nausea. Death has been reported following ingestion or injection of tilmicosin.
Avoid ingestion. Avoid direct skin and eye contact. In case of human exposure, consult a physician immediately and call +1-877-994-4883.
Note to the physician:
The cardiovascular system is the target of toxicity and should be monitored closely. The primary cardiac effects are tachycardia and decreased contractility. Cardiovascular toxicity may be due to calcium channel blockade.
See user safety warnings for additional information.
Important safety information: Tilmovet AC (tilmicosin phosphate): Not for human use. Keep out of reach of children. For use in drinking water of swine only. Do not treat swine within 7 days of slaughter. Exposure to tilmicosin in humans has been associated with chest pain, increased heart rate, dizziness, headache, and nausea. Death has been reported following ingestion or injection of tilmicosin. Avoid ingestion. Avoid direct skin and eye contact. In case of human exposure, call +1-877-994-4883 and consult a physician immediately. NOTE TO THE PHYSICIAN: The cardiovascular system is the target of toxicity and should be monitored closely. The primary cardiac effects are tachycardia and decreased contractility. Cardiovascular toxicity may be due to calcium channel blockade. Avoid the use of Tilmovet AC and other macrolides by any route, or the use of another macrolide immediately following the use of Tilmovet AC. Tilmovet AC is to be used by, or on the order of, a licensed veterinarian. The safety of tilmicosin has not been established in male swine intended for breeding purposes. Do not allow horses or other equines access to water containing tilmicosin. Do not inject Tilmovet AC as injection of tilmicosin has been shown to be fatal in swine and non-human primates, and may be fatal in horses and goats. Wear overalls, impervious gloves and eye protection when mixing and handling the product. Wash hands after handling the product. Wash affected parts if skin contact occurs. If accidental eye contact occurs, immediately rinse thoroughly with water. To report adverse effects, access medical information, or obtain additional product information, call +1-877-994-4883.

about us
Huvepharma®
Change country
The Huvepharma® distribution network covers 90 countries in 6 continents. Please select a country from the list below to see the products and services available in that region.
To view all products and services, select Global from the dropdown menu or click .
Change language
Huvepharma has a remarkable distribution network which covers 90 countries in 6 continents. To offer you the best services, we ask you to select your country.
Europe
Your browser is out of date!
Update your browser to view this website correctly. Update my browser now